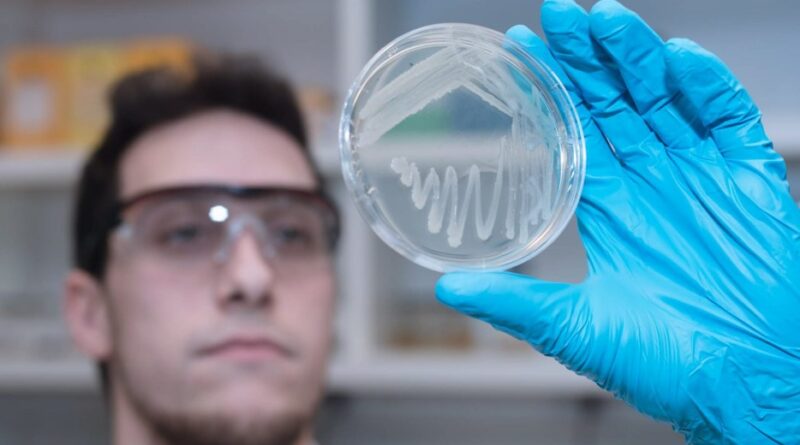

La contaminación ambiental por plásticos es uno de los principales motivos de la crisis ambiental que está viviendo el mundo entero, y de todos los residuos que generamos, sólo se recicla el 9%.
Frente a esta problemática que afecta directamente a nuestro ecosistema, junto al CONICET, la empresa Inmet, de la ciudad de Rosario, desarrolló una tecnología que produce PHB, un biomaterial 100% biodegradable y compostable.
Mediante la utilización de la bacteria Bacillus subtilis, la cual alimentamos con subproductos agroindustriales, generaron un biopolímero llamado PHB. Este biomaterial tiene múltiples aplicaciones, entre las que se encuentra el reemplazo de los plásticos de un sólo uso.
En 2023, inauguraron su propia planta piloto de fermentación, que se ubica en el campus de la Pontificia Universidad Católica Argentina en Rosario.
Siendo una plataforma única en la región, cuentan con fermentadores de hasta 1000 litros de capacidad, que permiten optimizar los procesos productivos de productos biotecnológicos de alto valor, como biofertilizantes, biosurfactantes y bioplásticos.
Desde sus inicios, en 2012, recibieron inversión de Bioceres S.A. y, recientemente, del fondo y company builder SF500. El apoyo ayudó a impulsar su principal objetivo que es “desarrollar una solución efectiva contra la crisis ambiental y acompañar a las organizaciones a mitigar el impacto de sus residuos”, según explican.
Seguí leyendo:
Córdoba presentó 8 de sus desarrollos para producción de biomateriales
El INTI ofreció su “know how” tecnológico a pymes metalúrgicas de Tres de Febrero